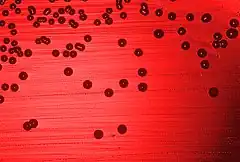
Description de cette image, également commentée ci-après

Haemophilus
| Domaine | Bacteria |
|---|---|
| Phylum | Pseudomonadota |
| Classe | Gammaproteobacteria |
| Ordre | Pasteurellales |
| Famille | Pasteurellaceae |
Genre
Haemophilus est un petit genre de bactéries, à gram négatif, de la famille des Pasteurellaceae. Les seize espèces de ce genre sont des bacilles immobiles, qui agissent en tant que parasites des muqueuses des humains et des animaux et peuvent provoquer des maladies. Le nom du groupe vient de son affinité particulière pour les milieux au sang ou à l'hémoglobine.
Espèces importantes d'un point de vue médical
- Haemophilus influenzae : cette espèce est, parmi les différentes espèces du genre Haemophilus, l'espèce pathogène la plus importante[1]. Elle peut à la fois faire partie de la flore commensale et être responsable d'infections respiratoires simples mais aussi capable de provoquer une maladie invasive entraînant des risques de décès[1].
Taxonomie
Le nom correct complet (avec auteur) de ce taxon est Haemophilus Winslow et al. 1917[2].
Étymologie
L'étymologie de ce gere est la suivante : Hae.mo.phi.lus. Gr. neut. n. haîma, sang (translittération latine haema); N.L. masculin adjectif suffixe -philus, ami, aimant; du Grec masculin adjectif philos, sur; N.L. masc. n. Haemophilus, aimant le sang[2].
Liste des espèces valides
Selon la base taxonomique LPSN (12 septembre 2023)[2], qui actualise les validations du Comité international de Systématique des procaryotes, le genre Haemophilus comprend 14 espèces publiées de manière valide et avec un nom correct.
- Haemophilus aegyptius corrig. (Trevisan 1889) Pittman et Davis 1950
- Haemophilus ducreyi (Neveu-Lemaire 1921) Bergey et al. 1923
- Haemophilus felis Inzana et al. 1999
- Haemophilus haemolyticus Bergey et al. 1923
- Haemophilus influenzae corrig. (Lehmann et Neumann 1896) Winslow et al. 1917
- Haemophilus massiliensis Lo et al. 2017
- Haemophilus paracuniculus Targowski et Targowski 1984
- Haemophilus parahaemolyticus Pittman 1953
- Haemophilus parainfluenzae Rivers 1922
- Haemophilus paraphrohaemolyticus Zinnemann et al. 1971
- Haemophilus piscium corrig. Snieszko et al. 1950
- Haemophilus pittmaniae Nørskov-Lauritsen et al. 2005
- Haemophilus seminalis Zheng et al. 2020
- Haemophilus sputorum Nørskov-Lauritsen et al. 2012
Espèces non valides
Selon la base taxonomique LPSN (12 septembre 2023)[2], des espèces d'Haemophilus ont été publiées de manière non valide. Leur nom est donc non valide mais peut être le nom préféré en attente d'une publication valide.
- "Haemophilus quentini" Mak et al. 2005
- "Haemophilus somnifer" Miles et al. 1972
Espèces synonymisées
Selon la LPSN (12 septembre 2023)[2], plusieurs espèces qui ont fait partie du genre Haemophilus se retrouvent désormais attribuées à un autre genre ou ont été synonymisées.
- Haemophilus actinomycetemcomitans (Klinger 1912) Potts et al. 1985 renommée Aggregatibacter actinomycetemcomitans (Klinger 1912) Nørskov-Lauritsen et Kilian 2006
- Haemophilus aphrophilus Khairat 1940 renommée Aggregatibacter aphrophilus (Khairat 1940) Nørskov-Lauritsen et Kilian 2006
- Haemophilus avium Hinz et Kunjara 1977 renommée Avibacterium avium (Hinz et Kunjara 1977) Blackall et al. 2005
- "Haemophilus bovis" (Hauduroy et al. 1937 renommée Moraxella bovis (Hauduroy et al. 1937) Murray 1948
- Haemophilus equigenitalis Taylor et al. 1983 renommée Taylorella equigenitalis (Taylor et al. 1983) Sugimoto et al. 1984
- Haemophilus haemoglobinophilus (Lehmann et Neumann 1907) Murray 1939 renommée Canicola haemoglobinophilus (Lehmann et Neumann 1907) Christensen et al. 2021
- Haemophilus paragallinarum Biberstein et White 1969 renommée Avibacterium paragallinarum (Biberstein et White 1969) Blackall et al. 2005
- Haemophilus paraphrophilus Zinnemann et al. 1968 renommée Aggregatibacter aphrophilus (Khairat 1940) Nørskov-Lauritsen et Kilian 2006
- Haemophilus parasuis Biberstein et White 1969 renommée Glaesserella parasuis (Biberstein et White 1969) Dickerman et al. 2020
- Haemophilus pleuropneumoniae corrig. Shope 1964 renommée Actinobacillus pleuropneumoniae (Shope 1964) Pohl et al. 1983
- Haemophilus segnis Kilian 1977 renommée Aggregatibacter segnis (Kilian 1977) Nørskov-Lauritsen et Kilian 2006
- Haemophilus vaginalis Gardner et Dukes 1955 renommée Gardnerella vaginalis (Gardner et Dukes 1955) Greenwood et Pickett 1980
Une autre espèce nommée ""Haemophilus canis"" mais jamais décrite formellement est considérée comme synonyme de l'espèce Haemophilus haemoglobinophilus[3].
Références
- 1 2 (en) Min-ling Zheng, Liang-hui Li, Bin Liu, Yu-bo Lin, Xiao-tuan Zhang, Cha Chen, Ping-Hua Qu et Jian Zeng, « Haemophilus seminalis sp. nov., isolated from human semen. », International Journal of Systematic and Evolutionary Microbiology, vol. 70, no 4, , p. 2581-2588 (DOI 10.1099/ijsem.0.004074)
- 1 2 3 4 5 List of Prokaryotic names with Standing in Nomenclature (LPSN), consulté le 12 septembre 2023.
- ↑ Biberstein 1990, p. 151.
Bibliographie
- (en) S. Baron et DM Musher, Medical Microbiology, The University of Texas Medical Branch at Galveston., (lire en ligne), chap. 30 (« Haemophilus species »)
- (en) LPSN : Haemophilus corrig. Winslow et al. 1917 (Approved Lists 1980) (consulté le )
- (en) E.L. Biberstein, « 13 - Haemophilus and Taylorella », dans G.R. Carter, John R. Cole, Jr, Diagnostic Procedure in Veterinary Bacteriology and Mycology, Elsevier Inc., , 5e éd. (ISBN 978-0-12-161775-2, DOI 10.1016/B978-0-12-161775-2.50017-7), p. 151-164
Liens externes
- Ressources relatives au vivant :
- Ressource relative à la santé :
- Portail de la microbiologie